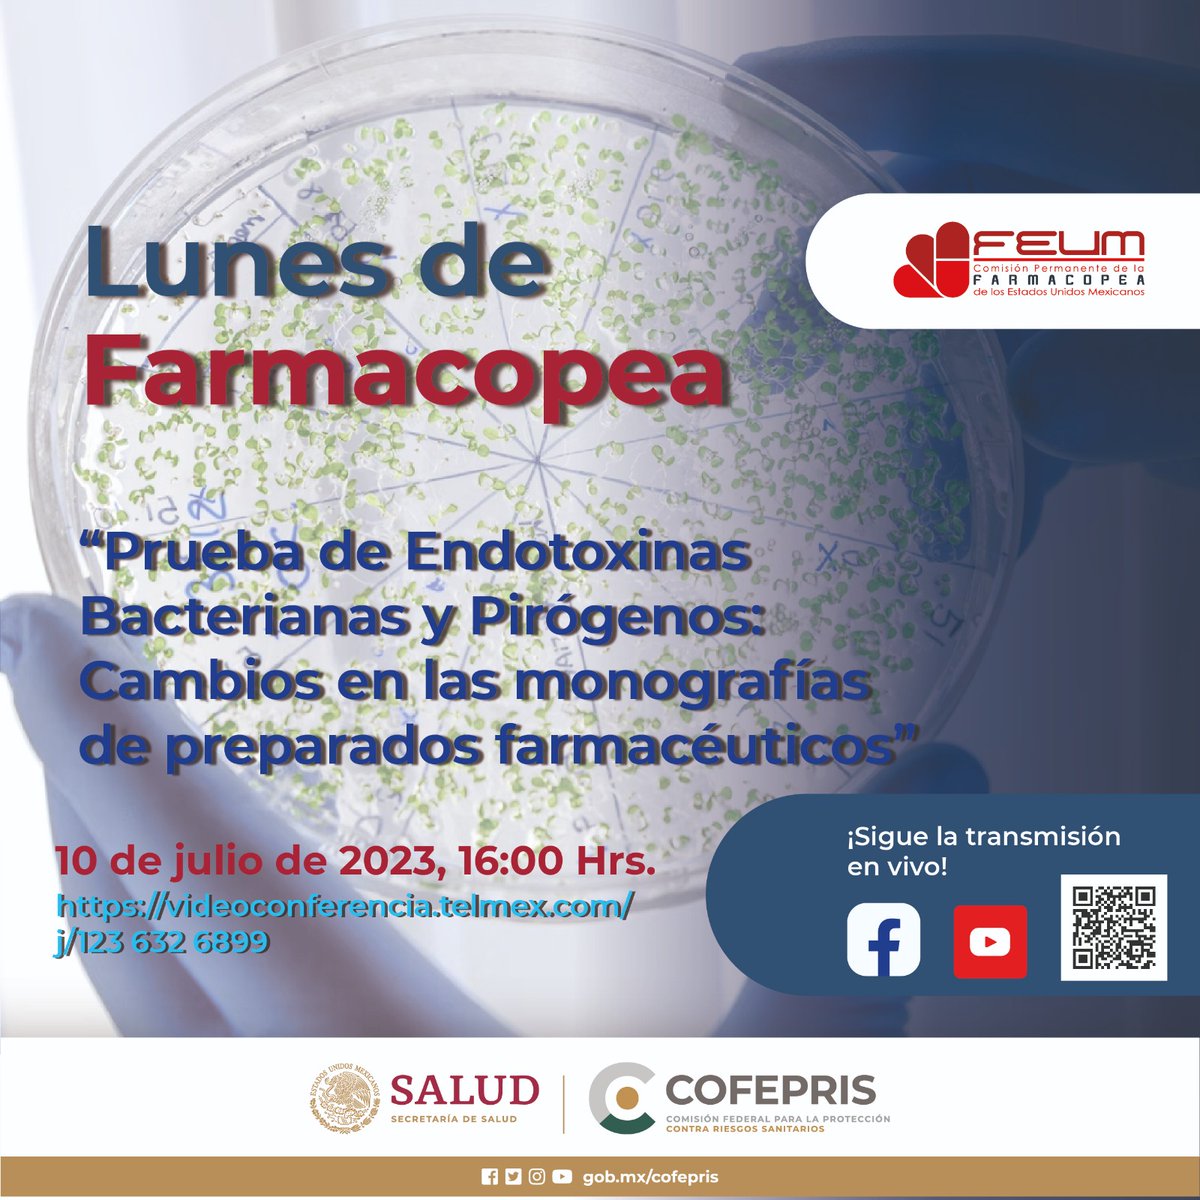
Mañana es #LunesDeFarmacopea! 💊
Recuerden que tenemos una cita, a las 16:00 hrs, para hablar de las “Pruebas de Endotoxinas Bacterias y Pirógenos: Cambios en las monografías de preparados farmacéuticos” conoce la importancia de estas pruebas y lo fundamentales que son.

FS SCIENTIA PHARMA
@fsscientia
Laboratorio Médico
Laboratorio Tercer Autorizado 🔬🧪💊🧬⚗️ de COFEPRIS
Centro de Investigación para el desarrollo y evaluación de medicamentos. 💉💊🧫
ID: 243679709
http://www.fsscientiapharma.com 27-01-2011 15:45:56
1,1K Tweet
139 Followers
505 Following

















Finalizando el #VRedIF2024 Meeting en Bogotá, Colombia; ha sido un gusto para FS Scientia Pharma ser patrocinador de este extraordinario evento, nos vemos en 2026 en Santiago, Chile. RedIF - Red Iberoamericana de Farmacometria